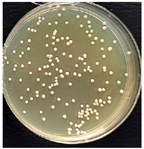
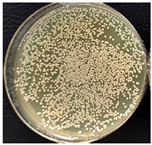
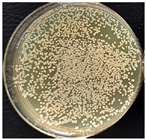

Characterization of Myrrh Extract Effect on Polylactide and Polypropylene Melt Spun Multifilament Yarn Structure and Properties
Abstract
1. Introduction
2. Materials and Methods
2.1. Materials
2.2. Methodology of Preparation of Ethanolic Myrrh Extract
2.3. Gas Chromatography–Mass Spectrometry Analysis of Ethanolic Myrrh Extract
2.4. Covering of Polymer Granules with Ethanolic Myrrh Extract
2.5. Melt Spinning of Multifilament Yarns
2.6. Linear Density of Melt Spun Multifilament Yarns
2.7. Scanning Electron Microscopy (SEM) Analysis of Melt Spun Multifilament Yarns
2.8. Mechanical Properties of Melt Spun Multifilament Yarns
2.9. Optical Properties of Melt Spun Multifilament Yarns
2.10. Thermal Behavior of Melt Spun Multifilament Yarns
2.11. Chemical Interactions Between Myrrh Resin and PP, PLA
2.12. Contact Angle on Melt Spun Multifilament Yarns
2.13. In Vitro Degradation Test of PLA Melt Spun Multifilament Yarns
2.14. Antibacterial Properties of PLA Melt Spun Multifilament Yarns
3. Results
3.1. Estimation of Biological Active Compounds in Ethanolic Myrrh Extract
3.2. The Influence of Myrrh Extract on the Linear Density and Mechanical Properties of Melt Spun Multifilament Yarns
3.3. Optical Analysis of Melt Spun Multifilament Yarns
3.4. Thermal Behavior of Melt Spun Multifilament Yarns
| Code of Sample | Tg (°C) | Tc (°C) | ∆Hc (J/g) | Tm1 (°C) | Tm2 (°C) | Tcc (°C) | ∆H m (J/g) | Crystallinity Xc (wt%) |
|---|---|---|---|---|---|---|---|---|
| PLA3 | 57.1 | 106 | 34.9 | 153.7 | 161.5 | 49.4 | 44.7 | 11 |
| PLA/M3 | 56.3 | 109.4 | 43.1 | 151.6 | 160.7 | 48.1 | 54.0 | 13 |
| PP3 | - | - | - | - | 162.9 | 120.1 | 102.9 | 49 |
| PP/M3 | - | - | - | - | 161.9 | 120.1 | 102.5 | 55 |
3.5. Raman Spectroscopy of Melt Spun Multifilament Yarns
3.6. Contact Angle on Melt Spun Multifilament Yarns
3.7. In Vitro Degradation Test of PLA Melt Spun Multifilament Yarns
3.8. Antibacterial Properties of PLA Melt Spun Multifilament Yarns
4. Conclusions
Author Contributions
Funding
Institutional Review Board Statement
Informed Consent Statement
Data Availability Statement
Acknowledgments
Conflicts of Interest
References
- Tabor, J.; Thompson, B.; Agcayazi, T.; Bozkurt, A.; Ghosh, T.K. Melt-Extruded Sensory Fibers for Electronic Textiles. Macromol. Mater. Eng. 2022, 307, 2100737. [Google Scholar] [CrossRef]
- Santos, D.M.; Correa, D.S.; Medeiros, E.S.; Oliveira, J.E.; Mattoso, L.H.C. Advances in Functional Polymer Nano fibers: From Spinning Fabrication Techniques to Recent Biomedical Applications. ACS Appl. Mater. Interfaces 2020, 12, 45673–45701. [Google Scholar] [CrossRef] [PubMed]
- Kopf, S.; Åkesson, D.; Skrifvars, M. Textile Fiber Production of Biopolymers—A Review of Spinning Techniques for Polyhydroxyalkanoates in Biomedical Applications. Polym. Rev. 2022, 63, 200–245. [Google Scholar] [CrossRef]
- Oh, T.H. Melt spinning and drawing process of PET side-by-side bicomponent fibers. J. Appl. Polym. Sci. 2006, 101, 1362–1367. [Google Scholar] [CrossRef]
- Zhang, Z.; Zhou, J.; Yu, S.; Wei, L.; Hu, Z.; Xiang, H.; Zhu, M. Melt-spun bio-based PLA-co-PET copolyester fibers with tunable properties: Synergistic effects of chemical structure and drawing process. Int. J. Biol. Macromol. 2023, 226, 670–678. [Google Scholar] [CrossRef]
- Xie, K.; Xu, S.; Xu, K.; Zhang, W.; Yu, S.; Wang, P.; Han, Z.; He, N.; Chen, P. Preparation and antibacterial properties of copper phthalate/polyethylene terephthalate composition fiber. Alex. Eng. J. 2023, 75, 271–278. [Google Scholar] [CrossRef]
- Seyhan, A.; Gunaydin, B.N.; Polat, Y.; Kilic, A.; Demir, A.; Avci, H. Improvement of polyethylene fiber wettability and mechanical properties through an environmentally sustainable spinning process. Int. J. Adhes. Adhes. 2022, 119, 103250. [Google Scholar] [CrossRef]
- Kanerva, M.; Puolakka, A.; Takala, T.M.; Elert, A.M.; Mylläri, V.; Jönkkäri, I.; Sarlin, E.; Seitsonen, J.; Ruokolainen, J.; Saris, P.; et al. Antibacterial polymer fibres by rosin compounding and melt-spinning. Mater. Today Commun. 2019, 20, 100527. [Google Scholar] [CrossRef]
- Liang, J.Z. Melt strength and stretching ratio of low-density polyethylene composites loaded with nanoscale zinc oxide. Adv. Ind. Eng. Polym. Res. 2020, 3, 129–135. [Google Scholar] [CrossRef]
- Gaidukovs, S.; Lyashenko, I.; Rombovska, J.; Gaidukova, G. Application of amber filler for production of novel polyamide composite fiber. Text. Res. J. 2016, 86, 2127–2139. [Google Scholar] [CrossRef]
- Demirhan, A.D.; Tuğral, S.; Sarıışık, M.; Göktaş, D.; Kartal, G.E. Investigation of polypropylene yarns containing silver nanoparticles: Fiber characteristics, yarn properties, and fabric performance analysis. J. Appl. Polym. Sci. 2024, 141, e55770. [Google Scholar] [CrossRef]
- Noh, S.; Jung, W.; Sim, S.; Son, H.S.; Choi, J.H.; Koo, J. Effect of Drawing Conditions on Crystal Structure and Mechanical Properties of Melt-Spun Polylactic Acid Fibers. Fibers Polym. 2023, 24, 483–488. [Google Scholar] [CrossRef]
- Xue, W.; Chen, P.; Wang, F.; Wang, L. Melt spinning of nano-hydroxyapatite and polycaprolactone composite fibers for bone scaffold application. J. Mater. Sci. 2019, 54, 8602–8612. [Google Scholar] [CrossRef]
- Shi, X.Q.; Ito, H.; Kikutani, T. Characterization on mixed-crystal structure and properties of poly(butylene adipate-co-terephthalate) biodegradable fibers. Polymer 2005, 46, 11442–11450. [Google Scholar] [CrossRef]
- Saigusa, K.; Takarada, W.; Kikutani, T. Improvement of the Mechanical Properties of Poly(Glycolic Acid) Fibers Through Control of Molecular Entanglements in the Melt Spinning Process. J. Macromol. Sci. Part B Phys. 2020, 59, 399–414. [Google Scholar] [CrossRef]
- Gahleitner, M.; Paulik, C. Polypropylene and Other Polyolefins; Elsevier Ltd.: Amsterdam, The Netherlands, 2012; ISBN 9780323358248. [Google Scholar]
- Tsioptsias, C.; Leontiadis, K.; Tzimpilis, E.; Tsivintzelis, I. Polypropylene nanocomposite fibers: A review of current trends and new developments. J. Plast. Film Sheeting 2021, 37, 283–311. [Google Scholar] [CrossRef]
- Adomavičiūtė, E.; Baltušnikaitė-Guzaitienė, J.; Juškaitė, V.; Žilius, M.; Briedis, V.; Stanys, S. Formation and characterization of melt-spun polypropylene fibers with propolis for medical applications. J. Text. Inst. 2018, 109, 278–284. [Google Scholar] [CrossRef]
- Radheshkumar, C.; Münstedt, H. Antimicrobial polymers from polypropylene/silver composites-Ag+ release measured by anode stripping voltammetry. React. Funct. Polym. 2006, 66, 780–788. [Google Scholar] [CrossRef]
- Erem, A.D.; Ozcan, G.; Skrifvars, M. In vitro assessment of antimicrobial polypropylene/zinc oxide nanocomposite fibers. Text. Res. J. 2013, 83, 2152–2163. [Google Scholar] [CrossRef]
- Esthappan, S.K.; Kuttappan, S.K.; Joseph, R. Thermal and mechanical properties of polypropylene/titanium dioxide nanocomposite fibers. Mater. Des. 2012, 37, 537–542. [Google Scholar] [CrossRef]
- Dastjerdi, R.; Mojtahedi, M.R.M. Multifunctional melt-mixed Ag/TiO2 nanocomposite PP fabrics: Water vapour permeability, UV resistance, UV protection and wear properties. Fibers Polym. 2013, 14, 298–303. [Google Scholar] [CrossRef]
- Dabrowska, I.; Fambri, L.; Pegoretti, A.; Slouf, M.; Vackova, T.; Kolarik, J. Spinning, drawing and physical properties of polypropylene nanocomposite fibers with fumed nanosilica. Express Polym. Lett. 2015, 9, 277–290. [Google Scholar] [CrossRef]
- Kara, S.; Ureyen, M.E.; Erdogan, U.H. Structural and Antibacterial Properties of PP/CuO Composite Filaments Having Different Cross Sectional Shapes. Int. Polym. Process. 2016, 31, 398–409. [Google Scholar] [CrossRef]
- Broda, J.; Slusarczyk, C.; Fabia, J.; Demsar, A. Formation and properties of polypropylene/stearic acid composite fibers. Text. Res. J. 2016, 86, 64–71. [Google Scholar] [CrossRef]
- Fredi, G. Melt-spun polypropylene filaments containing paraffin microcapsules for multifunctional hybrid yarns and smart thermoregulating thermoplastic composites. Express Polym. Lett. 2019, 2019, 1071–1087. [Google Scholar] [CrossRef]
- Cayla, A.; Campagne, C.; Rochery, M.; Devaux, E. Melt spun multifilament yarns of carbon nanotubes-based polymeric blends: Electrical, mechanical and thermal properties. Synth. Met. 2012, 162, 759–767. [Google Scholar] [CrossRef]
- Qi, Z.; Wang, B.; Sun, C.; Yang, M.; Chen, X.; Zheng, D.; Yao, W.; Chen, Y.; Cheng, R.; Zhang, Y. Comparison of Properties of Poly(Lactic Acid) Composites Prepared from Different Components of Corn Straw Fiber. Int. J. Mol. Sci. 2022, 23, 6746. [Google Scholar] [CrossRef] [PubMed]
- Devaux, E.; Aubry, C.; Campagne, C.; Rochery, M. PLA/Carbon Nanotubes Multifilament Yarns for Relative Humidity Textile Sensor. J. Eng. Fibers Fabr. 2011, 6, 155892501100600302. [Google Scholar] [CrossRef]
- John, M.J.; Anandjiwala, R.; Oksman, K.; Mathew, A.P. Melt-Spun Polylactic Acid Fibers: Effect of Cellulose Nanowhiskers on Processing and Properties. J. Appl. Polym. Sci. 2012, 127, 274–281. [Google Scholar] [CrossRef]
- Kanerva, M.; Mensah-Attipoe, J.; Puolakka, A.; Takala, T.M.; Hyttinen, M.; Layek, R.; Palola, S.; Yudin, V.; Pasanen, P.; Saris, P. Weathering of antibacterial melt-spun polyfilaments modified by pine rosin. Molecules 2021, 26, 876. [Google Scholar] [CrossRef] [PubMed]
- Sonseca, A.; Madani, S.; Muñoz-Bonilla, A.; Fernández-García, M.; Peponi, L.; Leonés, A.; Rodríguez, G.; Echeverría, C.; López, D. Biodegradable and Antimicrobial PLA–OLA Blends Containing Chitosan-Mediated Silver Nanoparticles with Shape Memory Properties for Potential Medical Applications. Nanomaterials 2020, 10, 1065. [Google Scholar] [CrossRef] [PubMed]
- Malafeev, K.V.; Moskalyuk, O.A.; Yudin, V.E.; Elena, N.; Ivan, E.M.; Gordina, E.M.; Bozhkova, S.A.; Ivan, E.M.; Gordina, E.M.; Bozhkova, S.A.; et al. Effects of silver nanoparticle on mechanical properties of polylactide composite yarns with different structure. J. Text. Inst. 2022, 113, 2523–2530. [Google Scholar] [CrossRef]
- Palanikumar, L.; Ramasamy, S.N.; Balachandran, C. Size-dependent antimicrobial response of zinc oxide nanoparticles. IET Nanobiotechnol. 2014, 8, 111–117. [Google Scholar] [CrossRef]
- Mohsenpour, H.; Pesce, M.; Patruno, A.; Bahrami, A.; Pour, P.M.; Farzaei, M.H. A review of plant extracts and plant-derived natural compounds in the prevention/treatment of neonatal hypoxic-ischemic brain injury. Int. J. Mol. Sci. 2021, 22, 833. [Google Scholar] [CrossRef]
- Chirila, L.; Constantinescu, G.C.; Danila, A.; Popescu, A.; Constantinescu, R.R.; Săndulache, I.M. Functionalization of textile materials with bioactive polymeric systems based on propolis and cinnamon essential oil. Ind. Textila 2020, 71, 186–192. [Google Scholar] [CrossRef]
- Moraczewski, K.; Pawłowska, A.; Stepczyńska, M.; Malinowski, R.; Kaczor, D.; Budner, B.; Gocman, K.; Rytlewski, P. Plant extracts as natural additives for environmentally friendly polylactide films. Food Packag. Shelf Life 2020, 26, 100593. [Google Scholar] [CrossRef]
- Salmas, C.E.; Giannakas, A.E.; Baikousi, M.; Leontiou, A.; Siasou, Z.; Karakassides, M.A. Development of Poly(L-Lactic Acid)/Chitosan/Basil Oil Active Packaging Films via a Melt-Extrusion Process Using Novel Chitosan/Basil Oil Blends. Processes 2021, 9, 88. [Google Scholar] [CrossRef]
- Llana-Ruiz-Cabello, M.; Pichardo, S.; Bermúdez, J.M.; Baños, A.; Núñez, C.; Guillamón, E.; Aucejo, S.; Cameán, A.M. Development of PLA films containing oregano essential oil (Origanum vulgare L. virens) intended for use in food packaging. Food Addit. Contam.-Part A Chem. Anal. Control Expo. Risk Assess. 2016, 33, 1374–1386. [Google Scholar] [CrossRef]
- Ahmed, J.; Mulla, M.Z.; Arfat, Y.A. Thermo-mechanical, structural characterization and antibacterial performance of solvent casted polylactide/cinnamon oil composite films. Food Control 2016, 69, 196–204. [Google Scholar] [CrossRef]
- Bolskis, E. Formation and Investigation of Mechanical, Thermal, Optical and Wetting Properties of Melt-Spun Multifilament Poly (lactic acid) Yarns with Added Rosins. Polymers 2022, 14, 379. [Google Scholar] [CrossRef]
- Bolskis, E.; Adomavičiūtė, E.; Griškonis, E.; Norvydas, V. Influence of Myrrh Extracts on the Properties of PLA Films and Melt-Spun Multifilament Yarns. Materials 2020, 13, 3824. [Google Scholar] [CrossRef] [PubMed]
- Massoud, A.; El Sisi, S.; Salama, O.; Massoud, A. Preliminary study of therapeutic efficacy of a new fasciolicidal drug derived from Commiphora molmol (MYRRh). Am. J. Trop. Med. Hyg. 2001, 65, 96–99. [Google Scholar] [CrossRef] [PubMed][Green Version]
- Mansouri, R.A.; Ahmad, A.; Roushdy, M.M.; Alshaibi, H.F.; Ragab, M. Pharmacological Studies on the Antidiabetic, Antioxidant, and Antimicrobial Efficacies of Commiphora myrrha Resin in Streptozotocin-Induced Diabetes in Rats: A Preclinical Study. J. Diabetes Res. 2023, 2023, 5478267. [Google Scholar] [CrossRef]
- Shameem, I.; Fahad, T. Phytochemical & therapeutic potentials of Murr makki (Commiphora myrrha): A review. Indian J. Appl. Res. 2018, 8, 102–104. [Google Scholar]
- Ajiteru, O.; Lee, O.J.; Kim, J.H.; Lee, Y.J.; Lee, J.S.; Lee, H.; Sultan, M.T.; Park, C.H. Fabrication and characterization of a myrrh hydrocolloid dressing for dermal wound healing. Colloids Interface Sci. Commun. 2022, 48, 100617. [Google Scholar] [CrossRef]
- ISO 2060:1994(en); Textiles—Yarn from Packages—Determination of Linear Density (Mass per Unit Length) by the Skein Method. ISO: Geneva, Switzerland, 1994.
- ISO 2062:2009(en); Textiles—Yarns from Packages—Determination of Single-End Breaking Force and Elongation at Break Using Constant Rate of Extension (CRE) tester (ISO 2062:2009). ISO: Geneva, Switzerland, 2009.
- Twarowska-Schmidt, K. Influence of drawing parameters on the properties of melt spun poly(lactic acid) fibres. Fibres Text. East. Eur. 2012, 96, 58–63. [Google Scholar]
- Phuphuak, Y.; Miao, Y.; Zinck, P.; Chirachanchai, S. Balancing crystalline and amorphous domains in PLA through star-structured polylactides with dual plasticizer/nucleating agent functionality. Polymer 2013, 54, 7058–7070. [Google Scholar] [CrossRef]
- Liu, S.; Wu, G.; Chen, X.; Zhang, X.; Yu, J.; Liu, M.; Zhang, Y.; Wang, P. Degradation behavior in vitro of carbon nanotubes (CNTs)/poly(lactic acid) (PLA) composite suture. Polymers 2019, 11, 1015. [Google Scholar] [CrossRef] [PubMed]
- Kong, Y.; Hay, J.N. The measurement of the crystallinity of polymers by DSC. Polymer 2002, 43, 3873–3878. [Google Scholar] [CrossRef]
- Krikštanavičienė, K.; Stanys, S.; Jonaitienė, V. Dependence of Polypropylene Yarn Mechanical Properties on Manufacturing Parameters. Mater. Sci. 2014, 20, 295–300. [Google Scholar] [CrossRef][Green Version]
- ISO 13781:2017(en); Implants for Surgery—Homopolymers, Copolymers and Blends on Poly(lactide)—In Vitro Degradation Testing. ISO: Geneva, Switzerland, 2017.
- Caronna, F.; Glimpel, N.; Paar, G.P.; Gries, T.; Blaeser, A.; Do, K.; Dolan, E.B.; Ronan, W. Manufacturing, characterization, and degradation of a poly(lactic acid) warp-knitted spacer fabric scaffold as a candidate for tissue engineering applications. Biomater. Sci. 2022, 10, 3793–3807. [Google Scholar] [CrossRef]
- Kim, J.W.; Park, S.; Sung, Y.W.; Song, H.J.; Yang, S.W. Evaluation of antiviral compounds from Commiphora molmol myrrh Evaluation of Antiviral Compounds from Commiphora molmol Myrrh Resin and Their Promising Application with Biochar. Preprints 2023, 13, 10549. [Google Scholar] [CrossRef]
- Batiha, G.E.S.; Wasef, L.; Teibo, J.O.; Shaheen, H.M.; Zakariya, A.M.; Akinfe, O.A.; Teibo, T.K.A.; Al-kuraishy, H.M.; Al-Garbee, A.I.; Alexiou, A.; et al. Commiphora myrrh: A phytochemical and pharmacological update. Naunyn-Schmiedeberg’s Arch. Pharmacol. 2023, 396, 405–420. [Google Scholar] [CrossRef] [PubMed]
- Tabur, M.A. Characterization of Myrrh Essential Oil with GC-MS and Investigation Antibacterial Effects on Salmonella spp. Süleyman Demirel Univ. Fac. Arts Sci. J. Sci. 2021, 16, 319–327. [Google Scholar] [CrossRef]
- Hanuš, L.O.; Řezanka, T.; Dembitsky, V.M. Myrrh–Commiphora Chemistry. Biomed. Pap. 2005, 149, 3–28. [Google Scholar] [CrossRef] [PubMed]
- Yu, W.; Wang, X.; Ferraris, E.; Zhang, J. Melt crystallization of PLA/Talc in fused filament fabrication. Mater. Des. 2019, 182, 108013. [Google Scholar] [CrossRef]
- Zhang, H.; Bai, H.; Wang, N.; Zhang, Q.; Fu, Q. The study of correlations among the process condition, structure and property for poly(l-lactide) fibers. J. Eng. Fiber. Fabr. 2023, 18, 15589250221148850. [Google Scholar] [CrossRef]
- Gajjar, C.R.; Stallrich, J.W.; Pasquinelli, M.A.; King, M.W. Process-Property Relationships for Melt-Spun Poly(lactic acid) Yarn. ACS Omega 2021, 6, 15920–15928. [Google Scholar] [CrossRef] [PubMed]
- Hossain, M.T.; Shahid, M.A.; Mahmud, N.; Habib, A.; Rana, M.M.; Khan, S.A.; Hossain, M.D. Research and application of polypropylene: A review. Discov. Nano 2024, 19, 2. [Google Scholar] [CrossRef] [PubMed]
- Biomax® Thermal 300-DuPont-Datasheet. Available online: https://polymer-additives.specialchem.com/product/a-dupont-biomax-thermal-300 (accessed on 27 November 2024).
- Alaburdaitė, R.; Krylova, V. Polypropylene film surface modification for improving its hydrophilicity for innovative applications. Polym. Degrad. Stab. 2023, 211, 110334. [Google Scholar] [CrossRef]
- Tolinski, M. Ultraviolet Light Protection and Stabilization. In Additives for Polyolefins; William Andrew Publishing: Oxford, UK, 2015; pp. 32–43. [Google Scholar] [CrossRef]
- Bones, D.L.; Henricksen, D.K.; Mang, S.A.; Gonsior, M. Appearance of strong absorbers and fluorophores in limonene-O Appearance of strong absorbers and fluorophores in limonene-O 3 secondary organic aerosol due to NH + 4 -mediated chemical aging over long time scales. J. Geophys. Res. Atmos. 2010, 115. [Google Scholar] [CrossRef]
- Fu, X.; Zhang, T.; Zhang, W.; Zhong, Y.; Fang, S.; Wang, G.; Li, Y.; Deng, Y.; Liu, X.; Li, H. Melt-blended PLA/curcumin-cross-linked polyurethane fi lm for enhanced UV-shielding ability. e-Polymers 2023, 23, 20230009. [Google Scholar] [CrossRef]
- Nanni, A.; Battegazzore, D.; Frache, A.; Messori, M. Thermal and UV aging of polypropylene stabilized by wine seeds wastes and their extracts. Polym. Degrad. Stab. 2019, 165, 49–59. [Google Scholar] [CrossRef]
- Ali, A.M.; El-Dessouky, H.M. An insight on the process–property relationships of melt spun polylactic acid fibers. Text. Res. J. 2019, 89, 4959–4966. [Google Scholar] [CrossRef]
- Yahyaoui, M.; Gordobil, O.; Herrera Díaz, R.; Abderrabba, M.; Labidi, J. Development of novel antimicrobial films based on poly(lactic acid) and essential oils. React. Funct. Polym. 2016, 109, 1–8. [Google Scholar] [CrossRef]
- Ferreira, R.R.; Farina, M.C.; Maia, A.; Torin, R.F.S. PLA Films Containing Montmorillonite Nanoclay–Citronella Essential Oil Hybrids for Potential Active Film Formulation. Macromol 2023, 3, 200–210. [Google Scholar] [CrossRef]
- Biswal, A.K.; Vashisht, I.; Khan, A.; Sharma, S.; Saha, S. Synthesis, characterization and antibacterial activity of thymol-loaded polylactic acid microparticles entrapped with essential oils of varying viscosity. J. Mater. Sci. 2019, 54, 9745–9758. [Google Scholar] [CrossRef]
- Strasakova, M.; Pummerova, M.; Filatova, K.; Sedlarik, V. Immobilization of Caraway Essential Oil in a Polypropylene Matrix for Antimicrobial Modification of a Polymeric Surface. Polymers 2021, 13, 906. [Google Scholar] [CrossRef] [PubMed]
- Qiao, B.; Teyssedre, G.; Laurent, C. Field and electron beam-induced luminescence phenomena in polypropylene thin films. In Proceedings of the IEEE 11th International Conference on the Properties and Applications of Dielectric Materials, 2015 (ICPADM), Sydney, NSW, Australia, 19–22 July 2015; pp. 196–199. [Google Scholar] [CrossRef]
- Marra, A. Assessment on the Effects of ZnO and Coated ZnO Particles on iPP and PLA Properties for Application in Food Packaging. Coatings 2017, 7, 29. [Google Scholar] [CrossRef]
- Cuiffo, M.A.; Snyder, J.; Elliott, A.M.; Romero, N.; Kannan, S.; Halada, G.P. Impact of the fused deposition (FDM) printing process on polylactic acid (PLA) chemistry and structure. Appl. Sci. 2017, 7, 579. [Google Scholar] [CrossRef]
- Gopanna, A.; Mandapati, R.N.; Thomas, S.P.; Rajan, K.; Chavali, M. Fourier transform infrared spectroscopy (FTIR), Raman spectroscopy and wide-angle X-ray scattering (WAXS) of polypropylene (PP)/cyclic olefin copolymer (COC) blends for qualitative and quantitative analysis. Polym. Bull. 2019, 76, 4259–4274. [Google Scholar] [CrossRef]
- Johnson-restrepo, B.; Banquet-tera, J.; Fontalvo-gomez, M.; Roman, R.J. Linear and Nonlinear Calibration Methods for Predicting Mechanical Properties of Polypropylene Pellets Using Raman Spectroscopy. Appl. Spectrosc. 2016, 70, 1118–1127. [Google Scholar] [CrossRef]
- Brody, R.H.; Edwards, H.G.M.; Pollard, A.M. Fourier Transform-Raman Spectroscopic Study of Natural Resins of Archaeological Interest. Biopolym. Orig. Res. Biomol. 2002, 67, 129–141. [Google Scholar] [CrossRef] [PubMed]
- Puchowicz, D.; Cieslak, M. Raman Spectroscopy in the Analysis of Textile Structures. In Recent Developments in Atomic Force Microscopy and Raman Spectroscopy for Materials Characterization; Pathak, C.S., Kumar, S., Eds.; IntechOpen: Rijeka, Croatia, 2021; Ch. 9; ISBN 978-1-83968-230-8. [Google Scholar]
- Edwards, H.G.M.; Falk, M.J. Fourier-transform Raman spectroscopic study of frankincense and myrrh. Spectrochim. Acta-Part A Mol. Biomol. Spectrosc. 1997, 53, 2393–2401. [Google Scholar] [CrossRef]
- Andreassen, E. Infrared and Raman Spectroscopy of Polypropylene; Springer: Berlin/Heidelberg, Germany, 1999; pp. 320–328. [Google Scholar] [CrossRef]
- Kuck, K.; Unterholzner, A.; Lipowicz, B.; Schwindl, S.; Jürgenliemk, G.; Schmidt, T.J.; Heilmann, J. Terpenoids from Myrrh and Their Cytotoxic Activity against HeLa Cells. Molecules 2023, 28, 1637. [Google Scholar] [CrossRef] [PubMed]
- Yu, W.; Liu, Y.; Wang, L.; Shi, J. Cu Nanoparticle-Modified High-Density Polyethylene Monofilament and Its Antifouling Performance on Fishing Netting. Int. J. Polym. Sci. 2019, 2019, 7250348. [Google Scholar] [CrossRef]
- Alshehri, M.A.; Baskaradoss, J.K.; Geevarghese, A.; Ramakrishnaiah, R.; Tatakis, D.N. Effects of myrrh on the strength of suture materials: An in vitro study. Dent. Mater. J. 2015, 34, 148–153. [Google Scholar] [CrossRef] [PubMed]
- Eshaghi, R.; Mohsenzadeh, M.; Ayala-Zavala, J.F. Bio-nanocomposite active packaging films based on carboxymethyl cellulose, myrrh gum, TiO2 nanoparticles and dill essential oil for preserving fresh-fish (Cyprinus carpio) meat quality. Int. J. Biol. Macromol. 2024, 263, 129991. [Google Scholar] [CrossRef] [PubMed]












| Code | Samples | Temperature at Heating Zones, °C | Speed of the Stretching Rolls, rpm | Drawing Ratio | |||
|---|---|---|---|---|---|---|---|
| S1 | S2 | S3 | S4 | ||||
| PP1.5 | PP | 205 | 100 | 116 | 139 | 150 | 1.5 |
| PP/M1.5 | PP + 10 wt% myrrh resin | ||||||
| PP2 | PP | 100 | 134 | 169 | 201 | 2 | |
| PP/M2 | PP + 10 wt% myrrh resin | ||||||
| PP2.5 | PP | 205 | 100 | 150 | 204 | 251 | 2.5 |
| PP/M2.5 | PP + 10 wt% myrrh resin | ||||||
| PP3 | PP | 100 | 168 | 237 | 301 | 3 | |
| PP/M3 | PP + 10 wt% myrrh resin | ||||||
| PLA1.5 | PLA | 205 | 100 | 116 | 139 | 150 | 1.5 |
| PLA/M1.5 | PLA+ 10 wt% myrrh resin | ||||||
| PLA2 | PLA | 100 | 134 | 169 | 201 | 2 | |
| PLA/M2 | PLA+ 10 wt% myrrh resin | ||||||
| PLA2.5 | PLA | 205 | 100 | 150 | 204 | 251 | 2.5 |
| PLA/M2.5 | PLA+ 10 wt% myrrh resin | ||||||
| PLA3 | PLA | 100 | 168 | 237 | 301 | 3 | |
| PLA/M3 | PLA+ 10 wt% myrrh resin | ||||||
| Liquid | Phys. Saline | Glycerol | Phys. Saline | Glycerol | Phys. Saline | Glycerol | Phys. Saline | Glycerol | Phys. Saline | Glycerol |
|---|---|---|---|---|---|---|---|---|---|---|
| Time | 0 | 10 | 20 | 60 | 120 | |||||
| Samples | ||||||||||
| PLA1.5 | 52.2 ± 1.4 | 81.1 ± 3.4 | - | 75.5 ± 3.6 | - | 73.9 ± 4.7 | - | 73.4 ± 4.0 | - | 72.2 ± 5.0 |
| PLA/M1.5 | 62.7 ± 2.7 | 85.4 ± 5.9 | 50.9 ± 4.7 | 83.1 ± 8.5 | 40.5 ± 5.6 | 81.9 ± 8.9 | - | 80.9 ± 8.2 | - | 80.1 ± 7.2 |
| PLA3 | 71.4 ± 1.6 | 87.6 ± 7.9 | 63.9 ± 4.0 | 83.1 ± 8.5 | 55.1 ± 4.1 | 81.9 ± 8.9 | 42.2 ± 6.5 | 80.9 ± 8 | - | 80.1 ± 7.2 |
| PLA/M3 | 69.6 ± 8.3 | 88.2 ± 5.5 | 63.6 ± 8.1 | 84.3 ± 6.1 | 54.7 ± 7.4 | 83.9 ± 5.3 | 33.1 ± 8.7 | 82.9 ± 6.1 | - | 81.9 ± 6.9 |
| PP1.5 | 54.8 ± 3.3 | 78.4 ± 5.2 | 34.8 ± 2.7 | 77.9 ± 5.3 | 18.1 ± 0.3 | 74.9 ± 3.2 | - | 71.9 ± 3 | - | 71.4 ± 2.4 |
| PP/M1.5 | 62.5 ± 1.9 | 79.6 ± 0.9 | 34.2 ± 4.6 | 76.1 ± 2 | 22.9 ± 2.1 | 75.4 ± 2.4 | - | 72.2 ± 2.7 | - | 72.1 ± 2.8 |
| PP3 | 60.6 ± 2.7 | 85.4 ± 5.7 | 50.3 ± 4.1 | 81.7 ± 7.5 | 42.9 ± 3.4 | 78.9 ± 6.7 | 37.3 ± 2.3 | 77.1 ± 5.3 | - | 77.0 ± 6.1 |
| PPM3 | 64.7 ± 5.1 | 92.5 ± 2.9 | 54.9 ± 6.7 | 88.5 ± 7.4 | 43.6 ± 1.1 | 88.1 ± 5.7 | 30.7 ± 5.5 | 87.9 ± 5.1 | - | 86.7 ± 4.8 |
| S. aureus, Bacteria Reduction = 84.42% | S. aureus Bacteria Reduction Didn’t Indicated | ||
![]() | ![]() | ![]() | ![]() |
| PLA/M3, 10−6 | Control, 10−6 | PLA3, 10−6 | Control, 10−6 |
Disclaimer/Publisher’s Note: The statements, opinions and data contained in all publications are solely those of the individual author(s) and contributor(s) and not of MDPI and/or the editor(s). MDPI and/or the editor(s) disclaim responsibility for any injury to people or property resulting from any ideas, methods, instructions or products referred to in the content. |
© 2024 by the authors. Licensee MDPI, Basel, Switzerland. This article is an open access article distributed under the terms and conditions of the Creative Commons Attribution (CC BY) license (https://creativecommons.org/licenses/by/4.0/).
Share and Cite
Bolskis, E.; Griškonis, E.; Marksa, M.; Ragelienė, L.; Adomavičiūtė, E. Characterization of Myrrh Extract Effect on Polylactide and Polypropylene Melt Spun Multifilament Yarn Structure and Properties. Materials 2024, 17, 5843. https://doi.org/10.3390/ma17235843
Bolskis E, Griškonis E, Marksa M, Ragelienė L, Adomavičiūtė E. Characterization of Myrrh Extract Effect on Polylactide and Polypropylene Melt Spun Multifilament Yarn Structure and Properties. Materials. 2024; 17(23):5843. https://doi.org/10.3390/ma17235843
Chicago/Turabian StyleBolskis, Evaldas, Egidijus Griškonis, Mindaugas Marksa, Lina Ragelienė, and Erika Adomavičiūtė. 2024. "Characterization of Myrrh Extract Effect on Polylactide and Polypropylene Melt Spun Multifilament Yarn Structure and Properties" Materials 17, no. 23: 5843. https://doi.org/10.3390/ma17235843
APA StyleBolskis, E., Griškonis, E., Marksa, M., Ragelienė, L., & Adomavičiūtė, E. (2024). Characterization of Myrrh Extract Effect on Polylactide and Polypropylene Melt Spun Multifilament Yarn Structure and Properties. Materials, 17(23), 5843. https://doi.org/10.3390/ma17235843